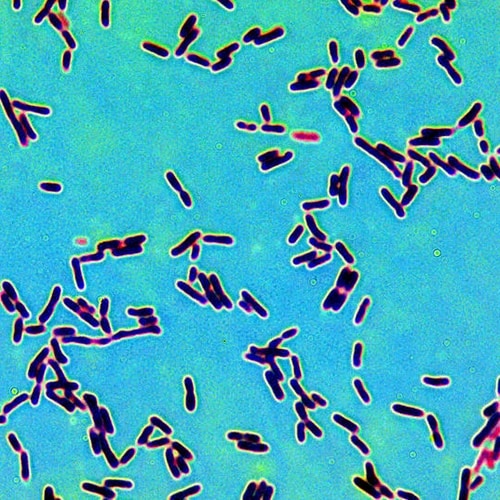
Malolactic Fermentation Experts

Industry Food and Beverage
We understand the critical importance of water quality and contamination control in the food and beverage industry to maintain the highest standards of safety, taste, and regulatory compliance while reducing cost, wastage, and streamlining operations. Our cutting-edge filtration and purification products and systems are meticulously designed to address these requirements so that clients can guarantee the utmost purity and integrity of their products.
Brewing

Applications
Utilities
Dairy

Applications
Utilities
Food production

Applications
Utilities
Non-alcoholic beverage

Utilities
Wine production

Applications
Utilities
Problems we solve
Contaminant removal
Contaminants such as bacteria, viruses, particulates, and chemical residues can compromise product safety and quality. BHF work to remove these contaminants, ensuring the production of safe and high-quality goods.
Regulatory compliance
Meeting stringent regulatory standards set by health and safety authorities can be challenging. Our advanced filtration solutions help companies comply with regulations by ensuring their products meet the required safety and quality standards, preventing issues specific to the law and market access.
Product consistency and taste
Variations in taste, texture, and appearance can negatively impact consumer trust and loyalty. BHF filtration solutions maintain consistent product quality by removing impurities from products, leading to uniform taste, texture, and appearance.
Sustainability and environmental impact
High water consumption and wastewater discharge can harm the environment and increase operational costs. Our solutions enable water recycling and reduce wastewater discharge, helping companies minimise their environmental footprint and save on water costs.
Process efficiency
Contaminants can clog equipment and disrupt production processes, leading to downtime and maintenance issues. Efficient filtration systems prevent clogging and contamination, ensuring smooth and uninterrupted production processes, thereby increasing productivity and reducing operational costs.
Shelf-life extension
Short shelf life due to microbial contamination and spoilage results in increased waste and reduced profitability. By removing spoilage-causing microorganisms, reducing waste, and enhancing profitability, we’re able to improve product shelf-life for our clients.
Related Projects

Australia’s Largest Dairy Manufacturer

Award Winning Queensland Brewer

Contract Bottling Facility